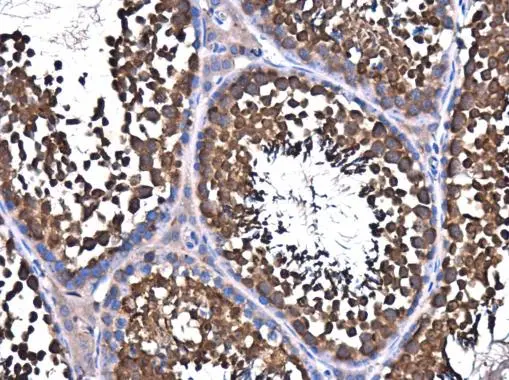
NSF antibody detects NSF protein at cytoplasm in mouse testis by immunohistochemical analysis. Sample: Paraffin-embedded mouse testis. NSF antibody (GTX110275) diluted at 1:500. 
 Antigen Retrieval: Citrate buffer, pH 6.0, 15 min

Sample (30 ug of whole cell lysate) A: 293T 7.5% SDS PAGE GTX110275 diluted at 1:1000
NSF antibody
GTX110275
ApplicationsWestern Blot, ImmunoHistoChemistry, ImmunoHistoChemistry Paraffin
Product group Antibodies
ReactivityHuman, Mouse, Rat
TargetNSF
Overview
- SupplierGeneTex
- Product NameNSF antibody
- Delivery Days Customer9
- Application Supplier NoteWB: 1:500-1:3000. IHC-P: 1:100-1:1000. *Optimal dilutions/concentrations should be determined by the researcher.Not tested in other applications.
- ApplicationsWestern Blot, ImmunoHistoChemistry, ImmunoHistoChemistry Paraffin
- CertificationResearch Use Only
- ClonalityPolyclonal
- Concentration0.27 mg/ml
- ConjugateUnconjugated
- Gene ID4905
- Target nameNSF
- Target descriptionN-ethylmaleimide sensitive factor, vesicle fusing ATPase
- Target synonymsDEE96, SEC18, SKD2, vesicle-fusing ATPase, N-ethylmaleimide-sensitive factor-like protein, N-ethylmaleimide-sensitive fusion protein, NEM-sensitive fusion protein, epididymis secretory sperm binding protein, vesicular-fusion protein NSF
- HostRabbit
- IsotypeIgG
- Protein IDP46459
- Protein NameVesicle-fusing ATPase
- ReactivityHuman, Mouse, Rat
- Storage Instruction-20°C or -80°C,2°C to 8°C
- UNSPSC41116161